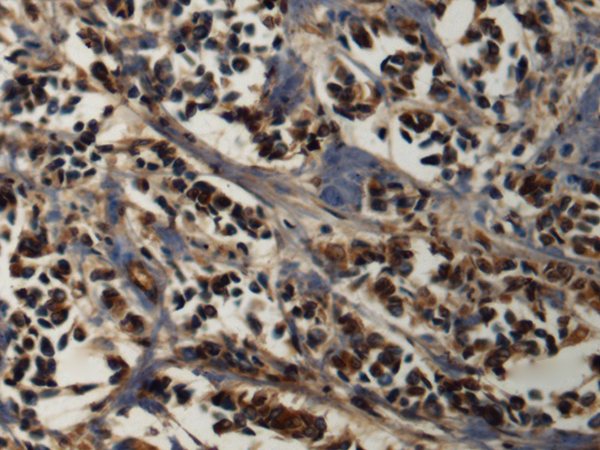
一抗

中文名稱: 兔抗POLD1多克隆抗體
英文名稱: Anti-POLD1 rabbit polyclonal antibody
別 名: DNA polymerase delta 1, catalytic subunit; CDC2; MDPL; POLD; CRCS10
相關(guān)類別: 一抗
儲(chǔ) 存: 冷凍(-20℃)
宿 主: Rabbit
抗 原: POLD1
反應(yīng)種屬: Human, Mouse, Rat
標(biāo) 記 物: Unconjugate
克隆類型: rabbit polyclonal
技術(shù)規(guī)格
|
Background: |
This gene encodes the 125-kDa catalytic subunit of DNA polymerase delta. DNA polymerase delta possesses both polymerase and 3' to 5' exonuclease activity and plays a critical role in DNA replication and repair. Alternatively spliced transcript variants have been observed for this gene, and a pseudogene of this gene is located on the long arm of chromosome 6. [provided by RefSeq, Mar 2012] |
|
Applications: |
ELISA, WB, IHC |
|
Name of antibody: |
POLD1 |
|
Immunogen: |
Fusion protein of human POLD1 |
|
Full name: |
DNA polymerase delta 1, catalytic subunit |
|
Synonyms: |
CDC2; MDPL; POLD; CRCS10 |
|
SwissProt: |
P28340 |
|
ELISA Recommended dilution: |
5000-10000 |
|
IHC positive control: |
Human breast cancer |
|
IHC Recommend dilution: |
150-300 |
|
WB Predicted band size: |
124 kDa |
|
WB Positive control: |
K562 cell lysate |
|
WB Recommended dilution: |
500-2000 |


 購(gòu)物車
購(gòu)物車 幫助
幫助
 021-54845833/15800441009
021-54845833/15800441009